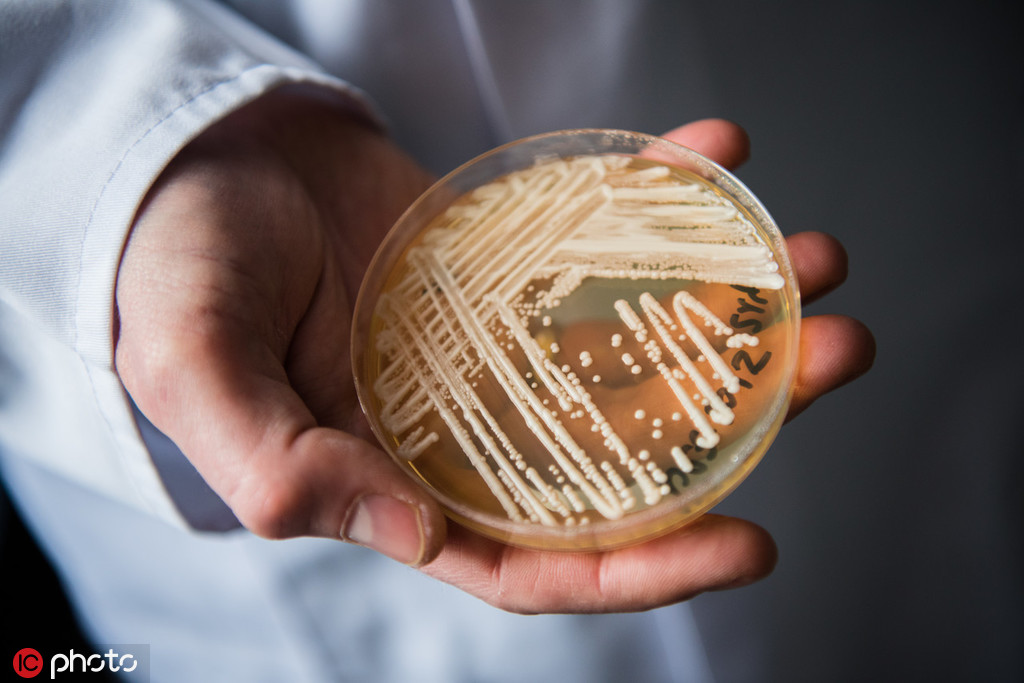
呼吸衰竭氧疗包括_呼吸衰竭用氧的原则_二型呼吸衰竭氧有效

二型呼吸衰竭氧有效-二型呼吸衰竭:被扼住的呼吸,离我们并不远的疾病
时间:2024-09-06 来源:网络整理 人气:
呼吸,这个我们每天都在做的动作,看似平常,却承载着生命的重量。可是,有些人的呼吸却像是被无形的手紧紧扼住,每一次吸气都像是在和死神搏斗。这就是二型呼吸衰竭患者的日常,他们的生活仿佛被按下了慢放键,空气中弥漫的不是氧气,而是绝望。

我曾亲眼目睹一个朋友在病床上挣扎的样子,那种无助和痛苦让我至今难以忘怀。他曾经是那么活泼开朗的一个人,笑声能点亮整个房间。可是,疾病像是一道无情的闪电,狠狠地劈在了他的身上。他的呼吸越来越急促,每一次呼吸似乎都在消耗他最后的力气。医生说,他需要氧气,大量的氧气,可是,氧气并不能解决所有问题。
二型呼吸衰竭,这个听起来就让人心惊胆战的词,其实离我们并不远。它就像是一个隐形的杀手,潜伏在我们的生活中,随时准备发动袭击。那些患者,他们的肺部已经无法正常工作,每一次呼吸都需要付出比常人更多的努力。他们需要氧气,但是氧气并不能让他们完全摆脱痛苦。

tokenpocket最新v1.8.7版下载:https://klbeyey.com/software/326.html
作者 克莱贝尔系统
教程资讯
教程资讯排行













